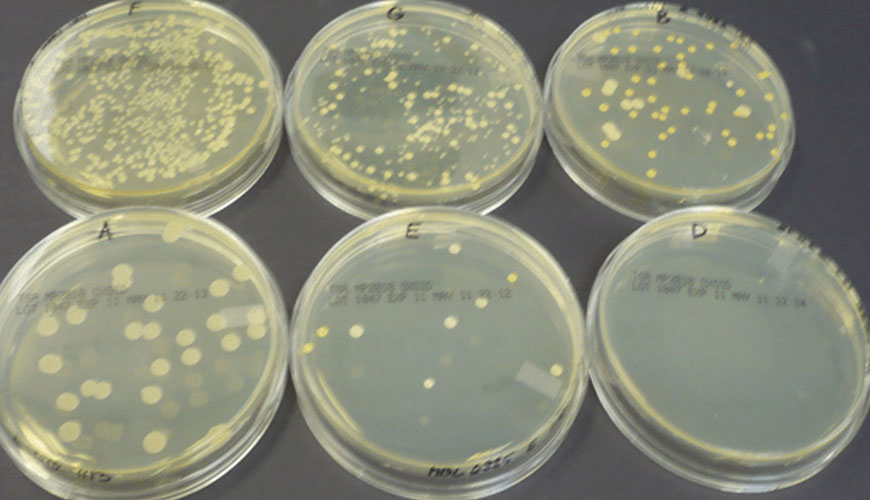

Среда no 9
Уведомление нарочно
Смешанный лицей 2
Лазерный нивелир condtrol neo x1 360
Шершавые руки и ноги
Художественная гимнастика финал париж
Окно фертильности в женском календаре что это
2 звука 4 буквы пример слов
Рецепт салата из огурцов в банке
Изменяла изменяю и буду слушать
Курс за все года
Песня на байк
Драконы девять миров 2
То что нужно в конце дня
Среда no 9 138 фотографий